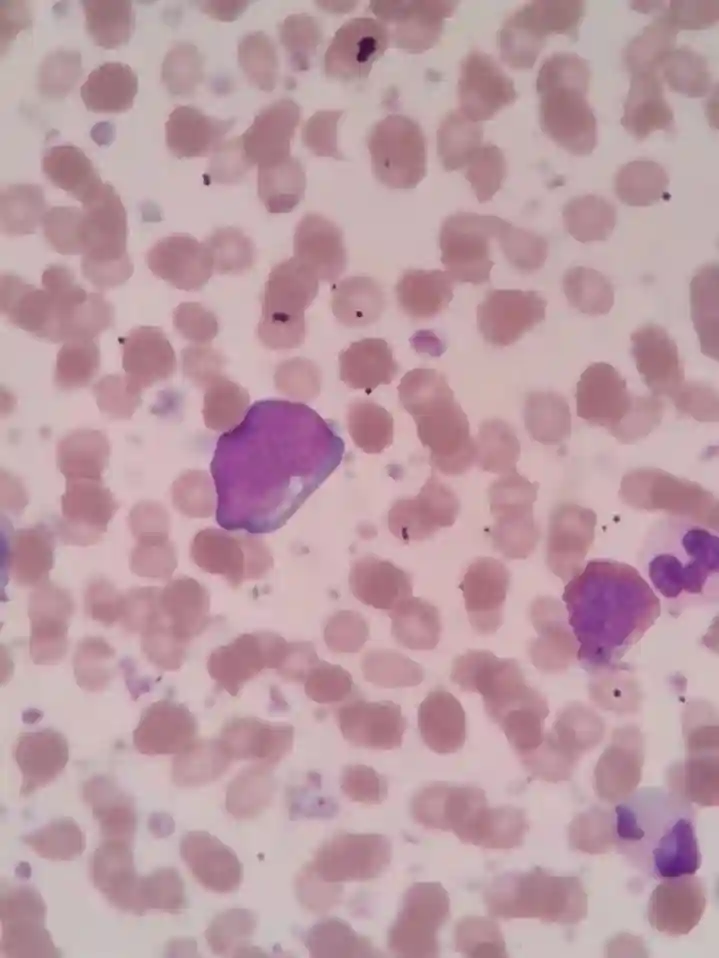
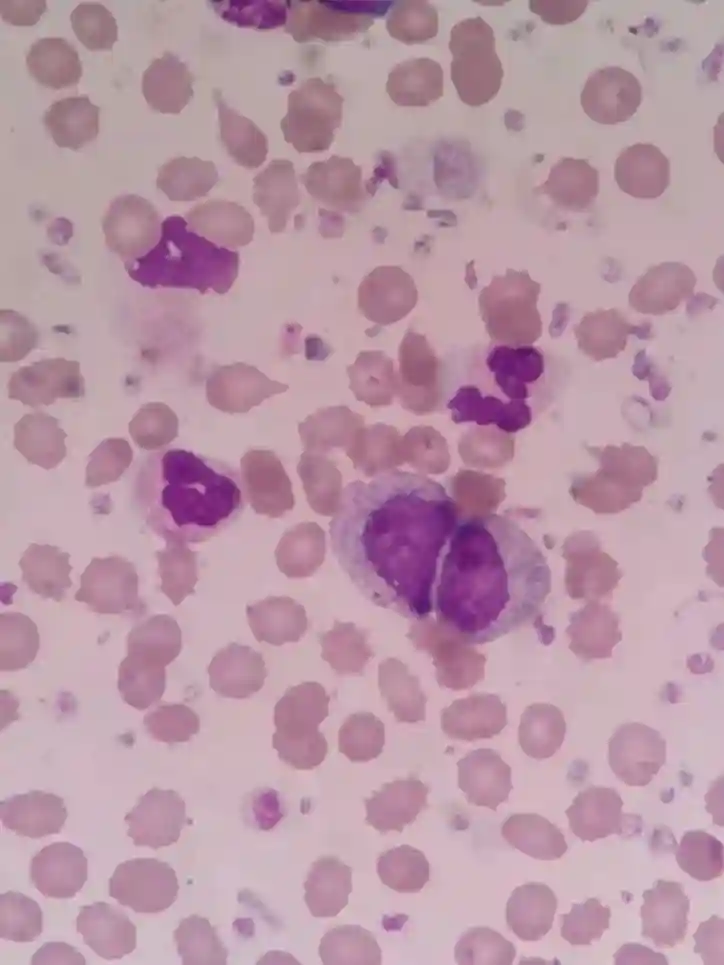
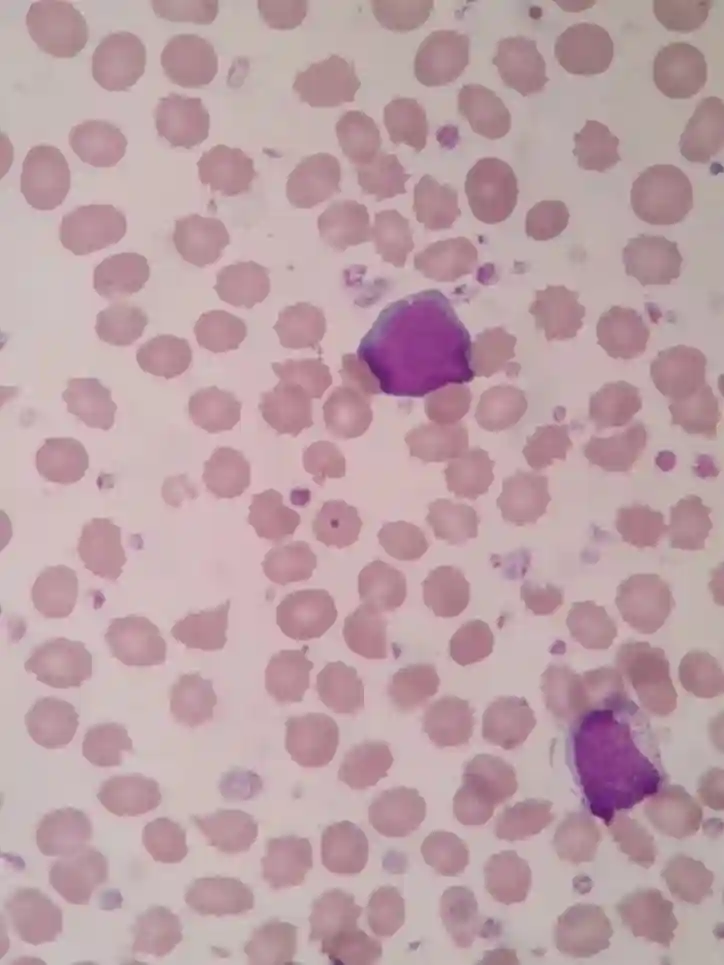
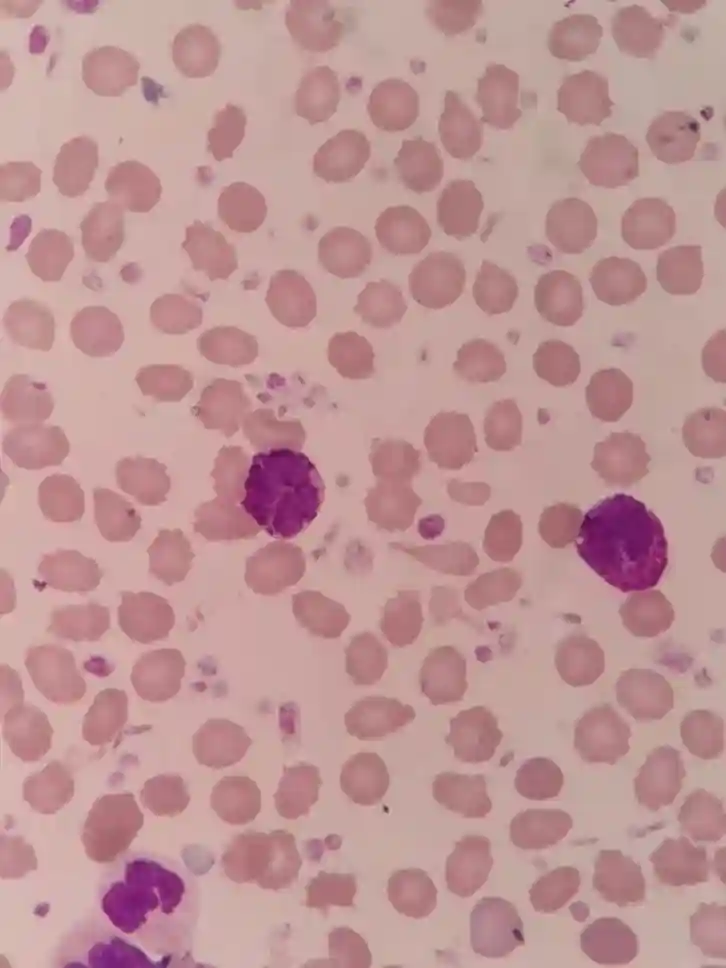
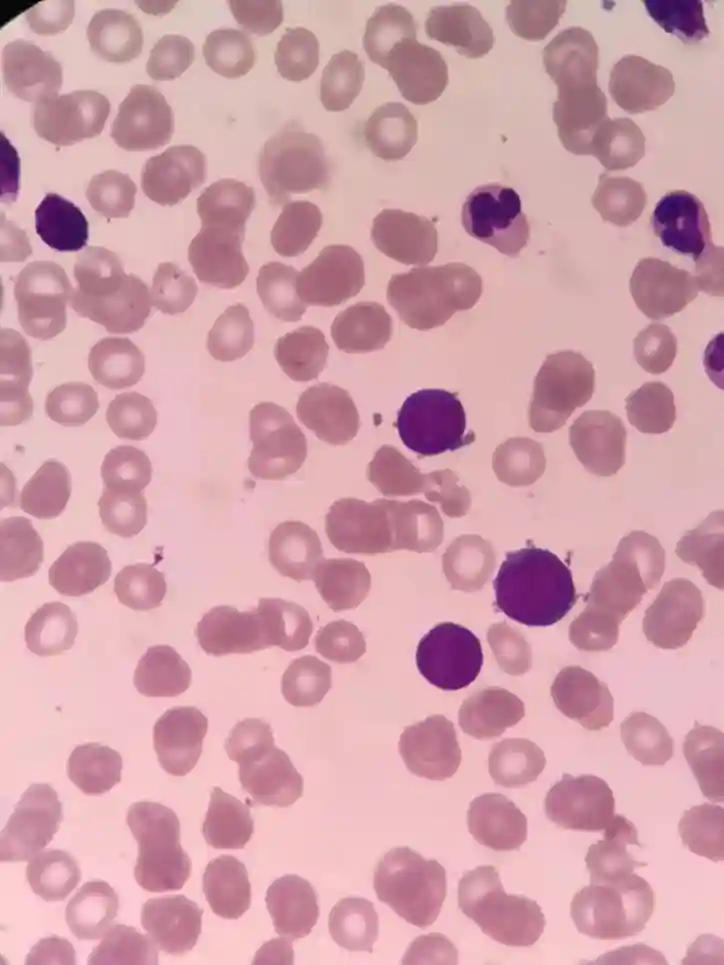
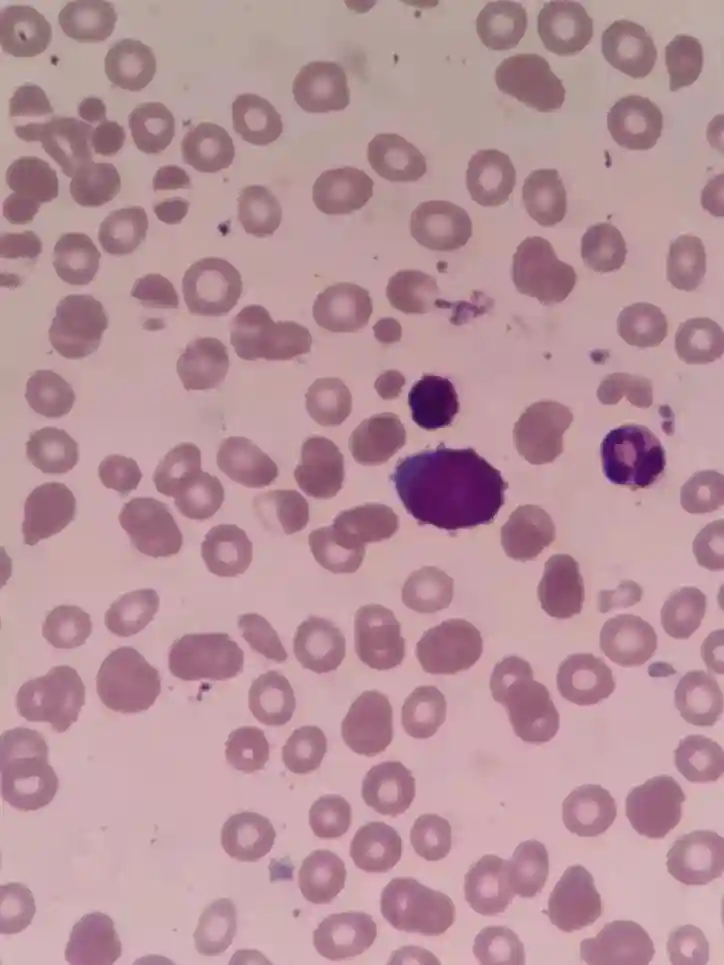
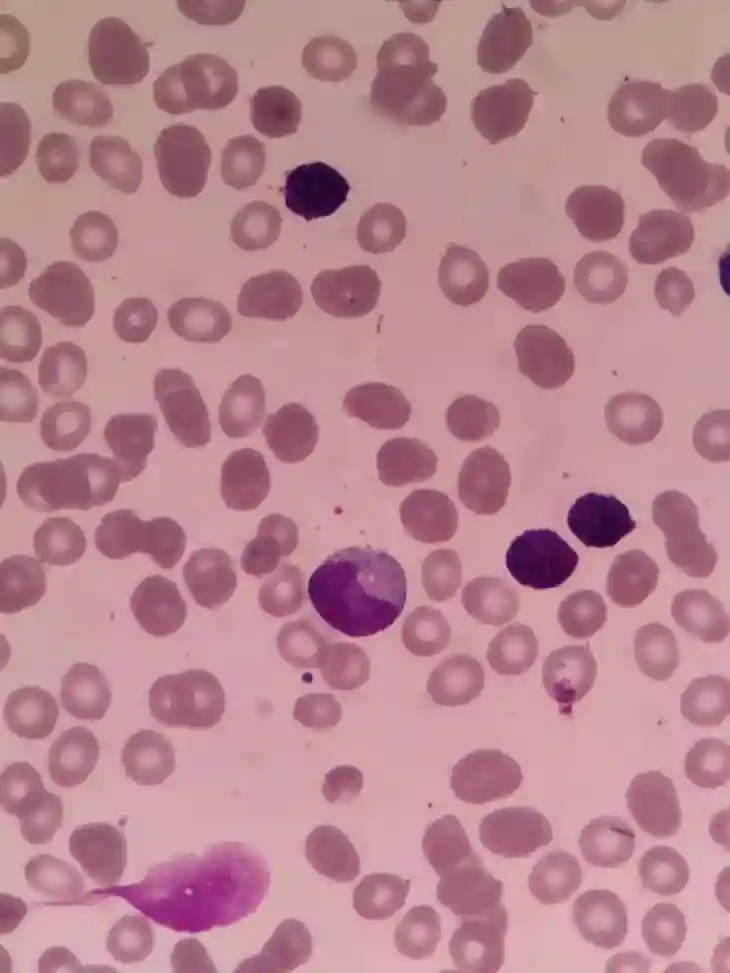

作者|马庆峰段德芳
单位|肥城市人民医院
前言
慢性粒细胞白血病(CML)属于慢性骨髓增殖性肿瘤(MPN)。源于造血干细胞克隆性异常。具有特异性Ph染色体和/或BCR-ABL1融合基因。全世界CML发病率为1-2例/10万,占全部白血病的15%-25%。可分为三期:初起为隐匿的慢性期(CP),随后进展为加速期(AP)或急变期(BP)。大部分患者诊断于慢性期,少数患者以急变期为首发表现。
案例经过
患者老年男性,因腹痛一月收住于外科。检查血常规发现白细胞数量明显增高,嗜碱性粒细胞数量增多,中度贫血,血小板数量明显增多。

散点图可见幼稚粒细胞增多。

推片复检,可见白细胞数量明显增多,原始细胞9%:

可见各阶段幼稚粒细胞:

嗜碱性粒细胞17%,血小板数量明显增多:
发出提示报告:


其他检查:

送检骨髓,可见增生明显活跃,原始细胞15%:

嗜碱性粒细胞13%:
考虑为慢性粒细胞白血病-加速期:

检验案例分析
流式细胞学可见14.68%异常髓系原始细胞,粒细胞比例升高。

活检考虑慢性粒细胞白血病(纤维化3级)。

BCR-ABL1(P210)融合基因阳性。

染色体核型:46,XY,t(9;22;11)(q34;;q13)

BCR-ABL1融合基因是诊断CML的金标志,结合临床表现和血与骨髓象即可诊断CML。确诊后分期至关重要,以决定预后及治疗规划。国内诊断标准CML的分期:
慢性期①外周血或骨髓中原始细胞10%;②未达到诊断加速期或急变期的标准。
加速期符合下列任何一项:①外周血或骨髓中原始细胞占10%-19%;②外周血嗜碱性粒细胞≧20%;③与治疗不相关的持续血小板减少(PLT100×109/L)或增高(PLT1000×109/L);④治疗过程中出现Ph+细胞基础上的其他克隆性染色体异常;⑤进行性脾脏增大或血细胞计数增高。
急变期符合下列任何一项:①外周血或骨髓中原始细胞≧20%;②骨髓活检原始细胞集聚;③髓外原始细胞浸润。
临床案例分析
患者一月前无明显诱因出现腹部疼痛,疼痛呈间断性,阵发性加剧,无发热,无腹胀,无黄疸,无腰背部疼痛,无尿频尿急。在家自用药物治疗,效果欠佳。为行进一步诊治,来院就诊。患者发病以来,一般状况可,神志清,精神可,饮食睡眠一般,大小便未见明显异常,体重无明显变化。以腹痛原因待查收治入院。
鉴别诊断:1.急性胰腺炎,2.急性胃炎,3.泌尿系结石,4.肠套叠。完善血常规、尿常规、心电图、CT检查进一步诊断。
血常规检查示白细胞、血小板明显增高。腹部CT示脾大。体检:体温、血压正常,心律齐,未及明显杂音,肝肾区无叩击痛,移动性浊音阴性,腹软,无胃肠型及蠕动波,下腹膨隆,叩鼓音,耻骨联合上可及脾下缘,触痛,四肢活动正常。患者白细胞、血小板增多、贫血伴有巨脾,初步考虑骨髓增殖性肿瘤可能。无明显原因的高白细胞和脾肿大是CML最突出的体征。需完善骨髓穿刺、活检、基因、流式细胞学等检查明确诊断。
鉴别诊断:
1.类白血病反应类白几乎都有原因可查的外周血白细胞增高、出现幼稚细胞。多见于感染、大手术后、重度烧伤、变态反应、癌症晚期等。
2.MPN其他类型慢粒(CML)、原发骨纤(PMF)、原发性血小板增多症(ET)、真红(PV)都是MPN的主要类型,都可出现脾肿大、外周血白细胞增高,甚至出现幼稚细胞,骨髓也常为多系增生。
3.Ph染色体阴性慢性髓系肿瘤慢中粒(CNL)、慢粒单(CMML)、不典型慢粒(aCML)、幼年型慢粒单(JMML)等均为Ph染色体阴性相关疾病。
骨髓细胞形态学检查不除外慢性粒细胞白血病-加速期,原始细胞比例15%,流式细胞学检查可见14.68%异常髓系原始细胞,BCR-ABL1(P210)融合基因阳性,JAK-2基因阴性,综合考虑为慢性粒细胞白血病-加速期。
检验案例总结
TKI(酪氨酸激酶抑制剂)治疗时代以来,已使令人生畏的恶性肿瘤慢性期CML转化为慢性病。然而TKI对加速期患者疗效仍差。
WHO2016修订版提出:虽然CML-AP在TKI(酪氨酸激酶抑制剂)治疗时代已较为少见,但加速期定义并未获得广泛共识。诊断标准基于血液学、细胞形态学、遗传学参数外加细胞遗传学演变和暂定的抗KTI治疗反应。
WHO第五版(2022)细化慢性髓细胞白血病危险因素,取消了加速期。因源自ABL1激酶突变和/或其它细胞遗传学异常的抗性以及急变期的发展代表了关键的疾病属性。因此,加速期在当前的分类中被省略,有利于强调与慢性期进展和对TKI耐药相关的高风险特征。
临床案例总结
慢性粒细胞白血病分慢性期、加速期及急变期。加速期可维持几个月到数年,常有发热、虚弱、进行性体重下降、骨骼疼痛,逐渐出现贫血和出血。脾持续或进行性肿大。
慢性粒细胞白血病治疗应着重于慢性期早期,避免疾病转化,力争细胞遗传学和分子生物学水平的缓解。一旦进入加速期或急变期则预后不良。完善BCR-ABL1激酶区突变了解是否合并酪氨酸激酶抑制剂耐药。
如既往未应用过酪氨酸激酶抑制剂,可考虑加量应用一代或二代酪氨酸激酶抑制剂,达到缓解后行异基因造血干细胞移植。患者MPLW515突变基因阴性,CALR1型及2型基因均阴性,JAK2V617F基因阴性,进一步支持慢性粒细胞白血病诊断。BCR-ABL1激酶区突变检测阴性,给予二代酪氨酸激酶抑制剂氟马替尼治疗,耐受良好。定期门诊复查,两个月后的血常规结果:


【参考文献】
[1]血液病诊断及疗效标准/沈悌赵永强主编.4版.北京:人民卫生出版社,2018
[2]临床检验诊断学图谱/王建中主编.北京:人民卫生出版社,2012
[3]慢性髓系肿瘤诊断学/卢兴国主编.北京:人民卫生出版社,2013
[4]血液病学/张之南郝玉书主编.2版.北京:人民卫生出版社,2011
声明:本平台旨在为医疗卫生专业人士传递更多医学信息。本平台发布的内容,不能以任何方式取代专业的医疗指导,也不应被视为诊疗建议。如该等信息被用于了解医学信息以外的目的,本平台不承担相关责任。本平台对发布的内容,并不代表同意其描述和观点。若涉及版权问题,烦请权利人与我们联系,我们将尽快处理。





